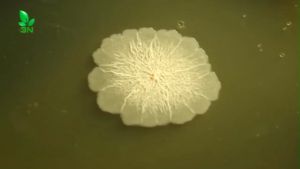
1 Kg Vi Sinh Đơn Dòng Bacillus Licheniformis Mật Độ 100 Tỷ CFU/gr Sử Dụng Cho Chăn Nuôi Và Nông Nghiệp

Thiết bị đựng nước uống chim 3/5L cho Vẹt và chim cút với móc treo thiết thực cho việc sử dụng tưới nước tại nhà và chuyên nghiệp
Đảm bảo chim của bạn luôn luôn có quyền truy cập vào freshing và nước sạch với nước uống chim của chúng tôi, thiết kế với hệ thống tưới nước tự động duy trì một mực nước liên tục mà không tràn. Sử dụng nhựa dày đã chọn, thiết bị đựng nước uống chim này có khả năng chống nứt và hư hỏng, có móc treo để dễ dàng đặt ngoài trời. Tuyệt vời cho những người đam mê chim, người nuôi chim bồ câu và người chăn nuôi gia cầm nhỏ, Máy tưới nước này phục vụ cho một loạt các loài gia cầm bao gồm vẹt, chim bồ câu, chim cút, gà và vịt. Thiết bị đựng nước uống chim 3/5L cho Vẹt và chim cút với móc treo thiết thực cho việc sử dụng tưới nước tại nhà và chuyên nghiệp. Các Tính năng: Đảm bảo chim của bạn luôn luôn có quyền truy cập vào freshing và nước sạch với nước uống chim của chúng tôi, thiết kế với hệ thống tưới nước tự động duy trì một mực nước liên tục mà không tràn. Sử dụng nhựa dày đã chọn, thiết bị đựng nước uống chim này có khả năng chống nứt và hư hỏng, có móc treo để dễ dàng đặt ngoài trời. Tuyệt

Postman Tool Store
Đánh giá

Có thể bạn cũng thích

Tinh tế hồ cá cảnh quan cỏ nhân tạo cảnh quan hồ cạn tôm cỏ tượng hồ cá môi trường sống kiểu dáng

Bơm thay thế cho đài phun nước cho mèo đài phun nước cho thú cưng bơm siêu êm với giác hút 3 cấp độ điều chỉnh lưu lượng nước

Thức ăn hạt dành cho Chó Luvcare (Giống bé/Giống vừa/ Giống lớn) gói 2kg

sữa dinh dưỡng pha sẵn DoggyMan dành cho chó mèo từ 2 tháng tuổi - T3 PETS SHOP

Dây ống oxy co2 dẻo nhiều màu dây silicone pvc dẫn khí thay nước bể cá

Bàn Chải Tắm Cho Chó Mèo Bằng Silicon Mềm Mại Có Chỗ Đựng Sữa Tắm Tạo Bọt
1 Kg Vi Sinh Đơn Dòng Bacillus Licheniformis Mật Độ 100 Tỷ CFU/gr Sử Dụng Cho Chăn Nuôi Và Nông Nghiệp

Aqua RX 5000 chế phẩm vi sinh Thái Lan 365 ngày không cần thay nước (hủ 50 viên)

Tông Đơ Điện Cho Thú Cưng Có Dây Chuyên Nghiệp Tông Đơ Lông Cừu Cạo Công Suất W Máy Cắt Lông Cho Chó Thỏ Lông Vàng Chó Lớn

MONLEYTA | Thảm ngủ cho chó cỡ lớn cỡ nhỏ đa năng thoáng khí chống thấm nước mùa hè mùa đông mùa xuân mùa thu dùng cho chó cưng

Đồ chơi Gà cho thú cưng cắn Đồ chơi cắn ngặm cho Chó mèo

































